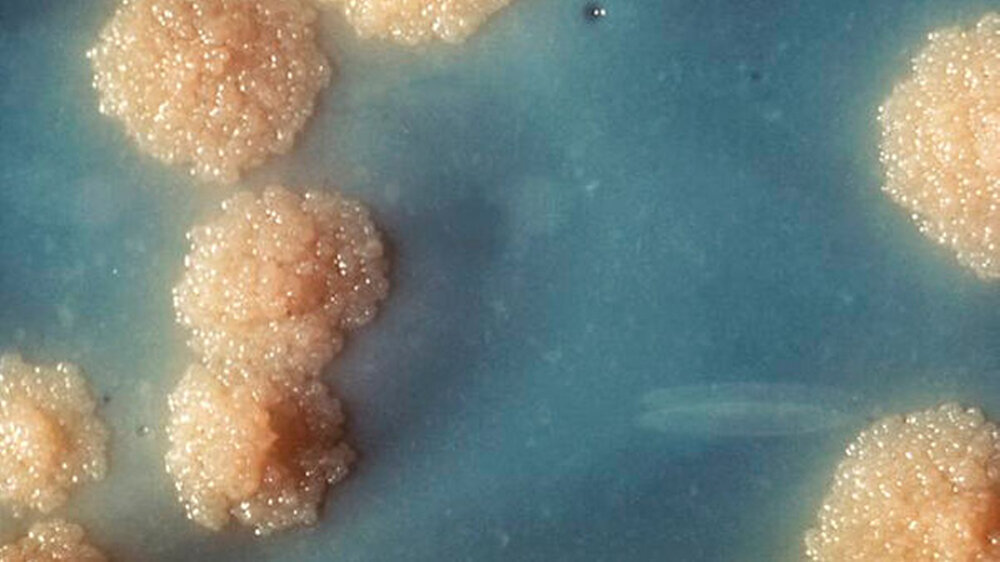

Tuberkulose: Flüchtlinge infizieren sich unterwegs
Ein erheblicher Anteil des Anstiegs geht nach Angaben des Robert Koch-Instituts (RKI) darauf zurück, dass die Gesundheitsämter wegen der großen Flüchtlingszahlen mehr Reihenuntersuchungen machen und so mehr Kranke aufspüren. Die RKI-Zahlen zeigen, dass im vergangenen Jahr in Deutschland bei 5.865 Menschen die Diagnose TB gestellt wurde.
Das RKI registrierte rund 1.250 Fälle (Stichtag: 1. März 2016). Das ist eine Steigerung um mehr als 30 Prozent. 2014 waren es ungefähr 400 gewesen. Weltweit ist die geschätzte Zahl der Neuerkrankungen um 600.000 (+6,7 Prozent) auf 9,6 Millionen gestiegen. Experten gehen trotzdem weiter davon aus, dass das Ansteckungsrisiko für Tuberkulose in der Allgemeinbevölkerung sehr gering ist.
Viele Flüchtlinge infizieren sich unterwegs
Gentests bei TB-Erregern weisen darauf hin, dass sich manche Flüchtlinge erst auf der Flucht und in der Enge der Flüchtlingslager mit Tuberkulose infizieren. Ihr Immunsystem sei durch die anstrengende Flucht meist angeschlagen, sagte ein Sprecher der Deutschen Lepra- und Tuberkulosehilfe (DAHW). "Und bei so vielen Menschen auf einem Raum ist eine Infektion dann kein Wunder." Die Flüchtlinge seien daher „nicht nur Opfer der Krankheit, sondern auch der unerträglichen Umstände auf ihrer Flucht“, sagte DAHW-Geschäftsführer Burkard Kömm. Je nach Region unterscheiden sich die Bakterien in ihrem genetischen Fingerabdruck. Forscher können so erkennen, wo sich die Menschen angesteckt haben.
LAGeSo kündigt Betrieb der zentralen Impfstelle für Asylsuchende
Fast zeitgleich zur Veröffentlichung der aktuellen Zahlen der Tuberkulosefälle in Deutschland hatte das Landesamt für Gesundheit und Soziales (LAGeSo) in Berlin die Vereinbarung mit der Kassenärztlichen Vereinigung (KV) zum Betrieb der Zentralen Impfstelle für Asylsuchende gekündigt. „Unlogisch und unverantwortlich“, kritisierte KV-Vorsitzende Angelika Prehn den Beschluss im Deutschen Ärzteblatt Online.
Laut Prehn kamen täglich bis vor kurzem bis zu 300 Patienten, um sich impfen zu lassen. „Dann hat das LAGeSo aufgehört, Flüchtlinge zu uns zu schicken, und es darüber hinaus auch nicht geschafft oder nicht gewollt, Impflücken bei bereits anwesenden Asylsuchenden durch eine zielgerichtete Steuerung hin zur Zentralen Impfstelle zu schließen“, sagte Prehn.
In der Regel wird die Krankheit von Mensch zu Mensch durch Tröpfcheninfektion übertragen.
Artikel nicht gefunden id_extern: typo3-import-article-326
<interactive-element xmlns:ns3="http://www.w3.org/1999/xlink" ns3:href="censhare:///service/assets/asset/id/" ns3:role="censhare:///service/masterdata/asset_rel_typedef;key=actual."/>
Alle wichtigen Fakten zur Tuberkulose lesen Sie $(LC322298:hier!)$